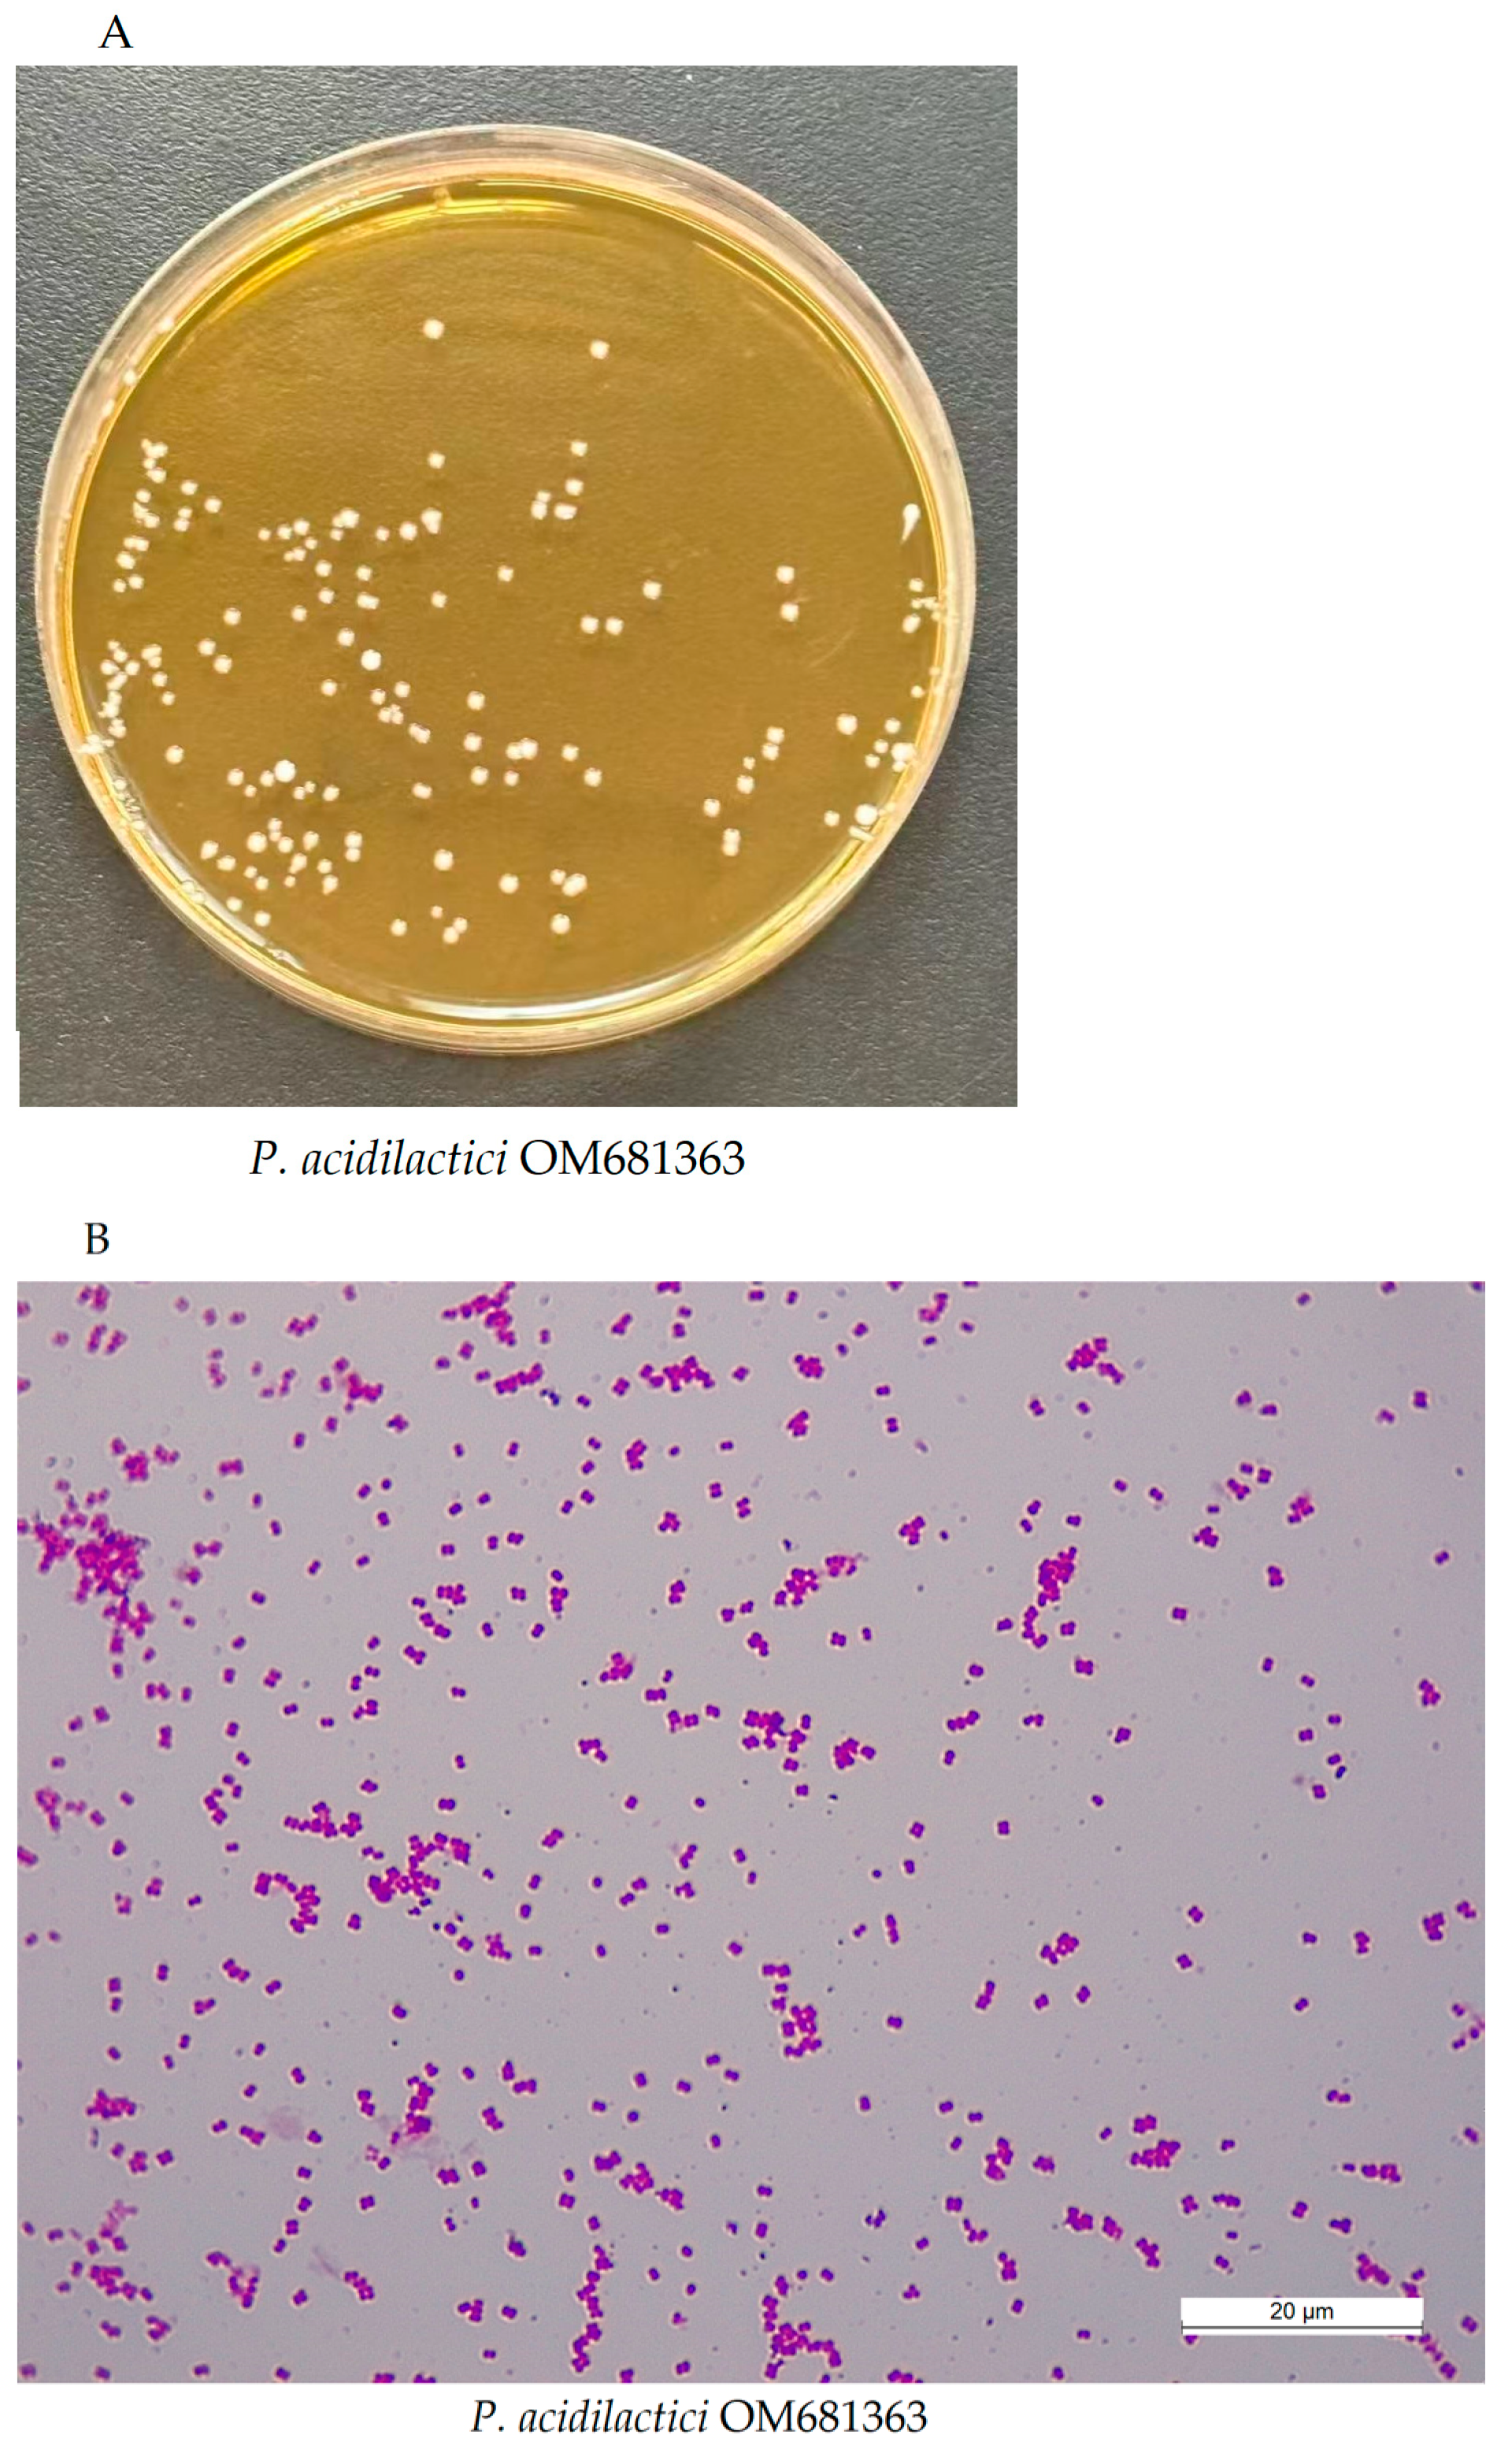
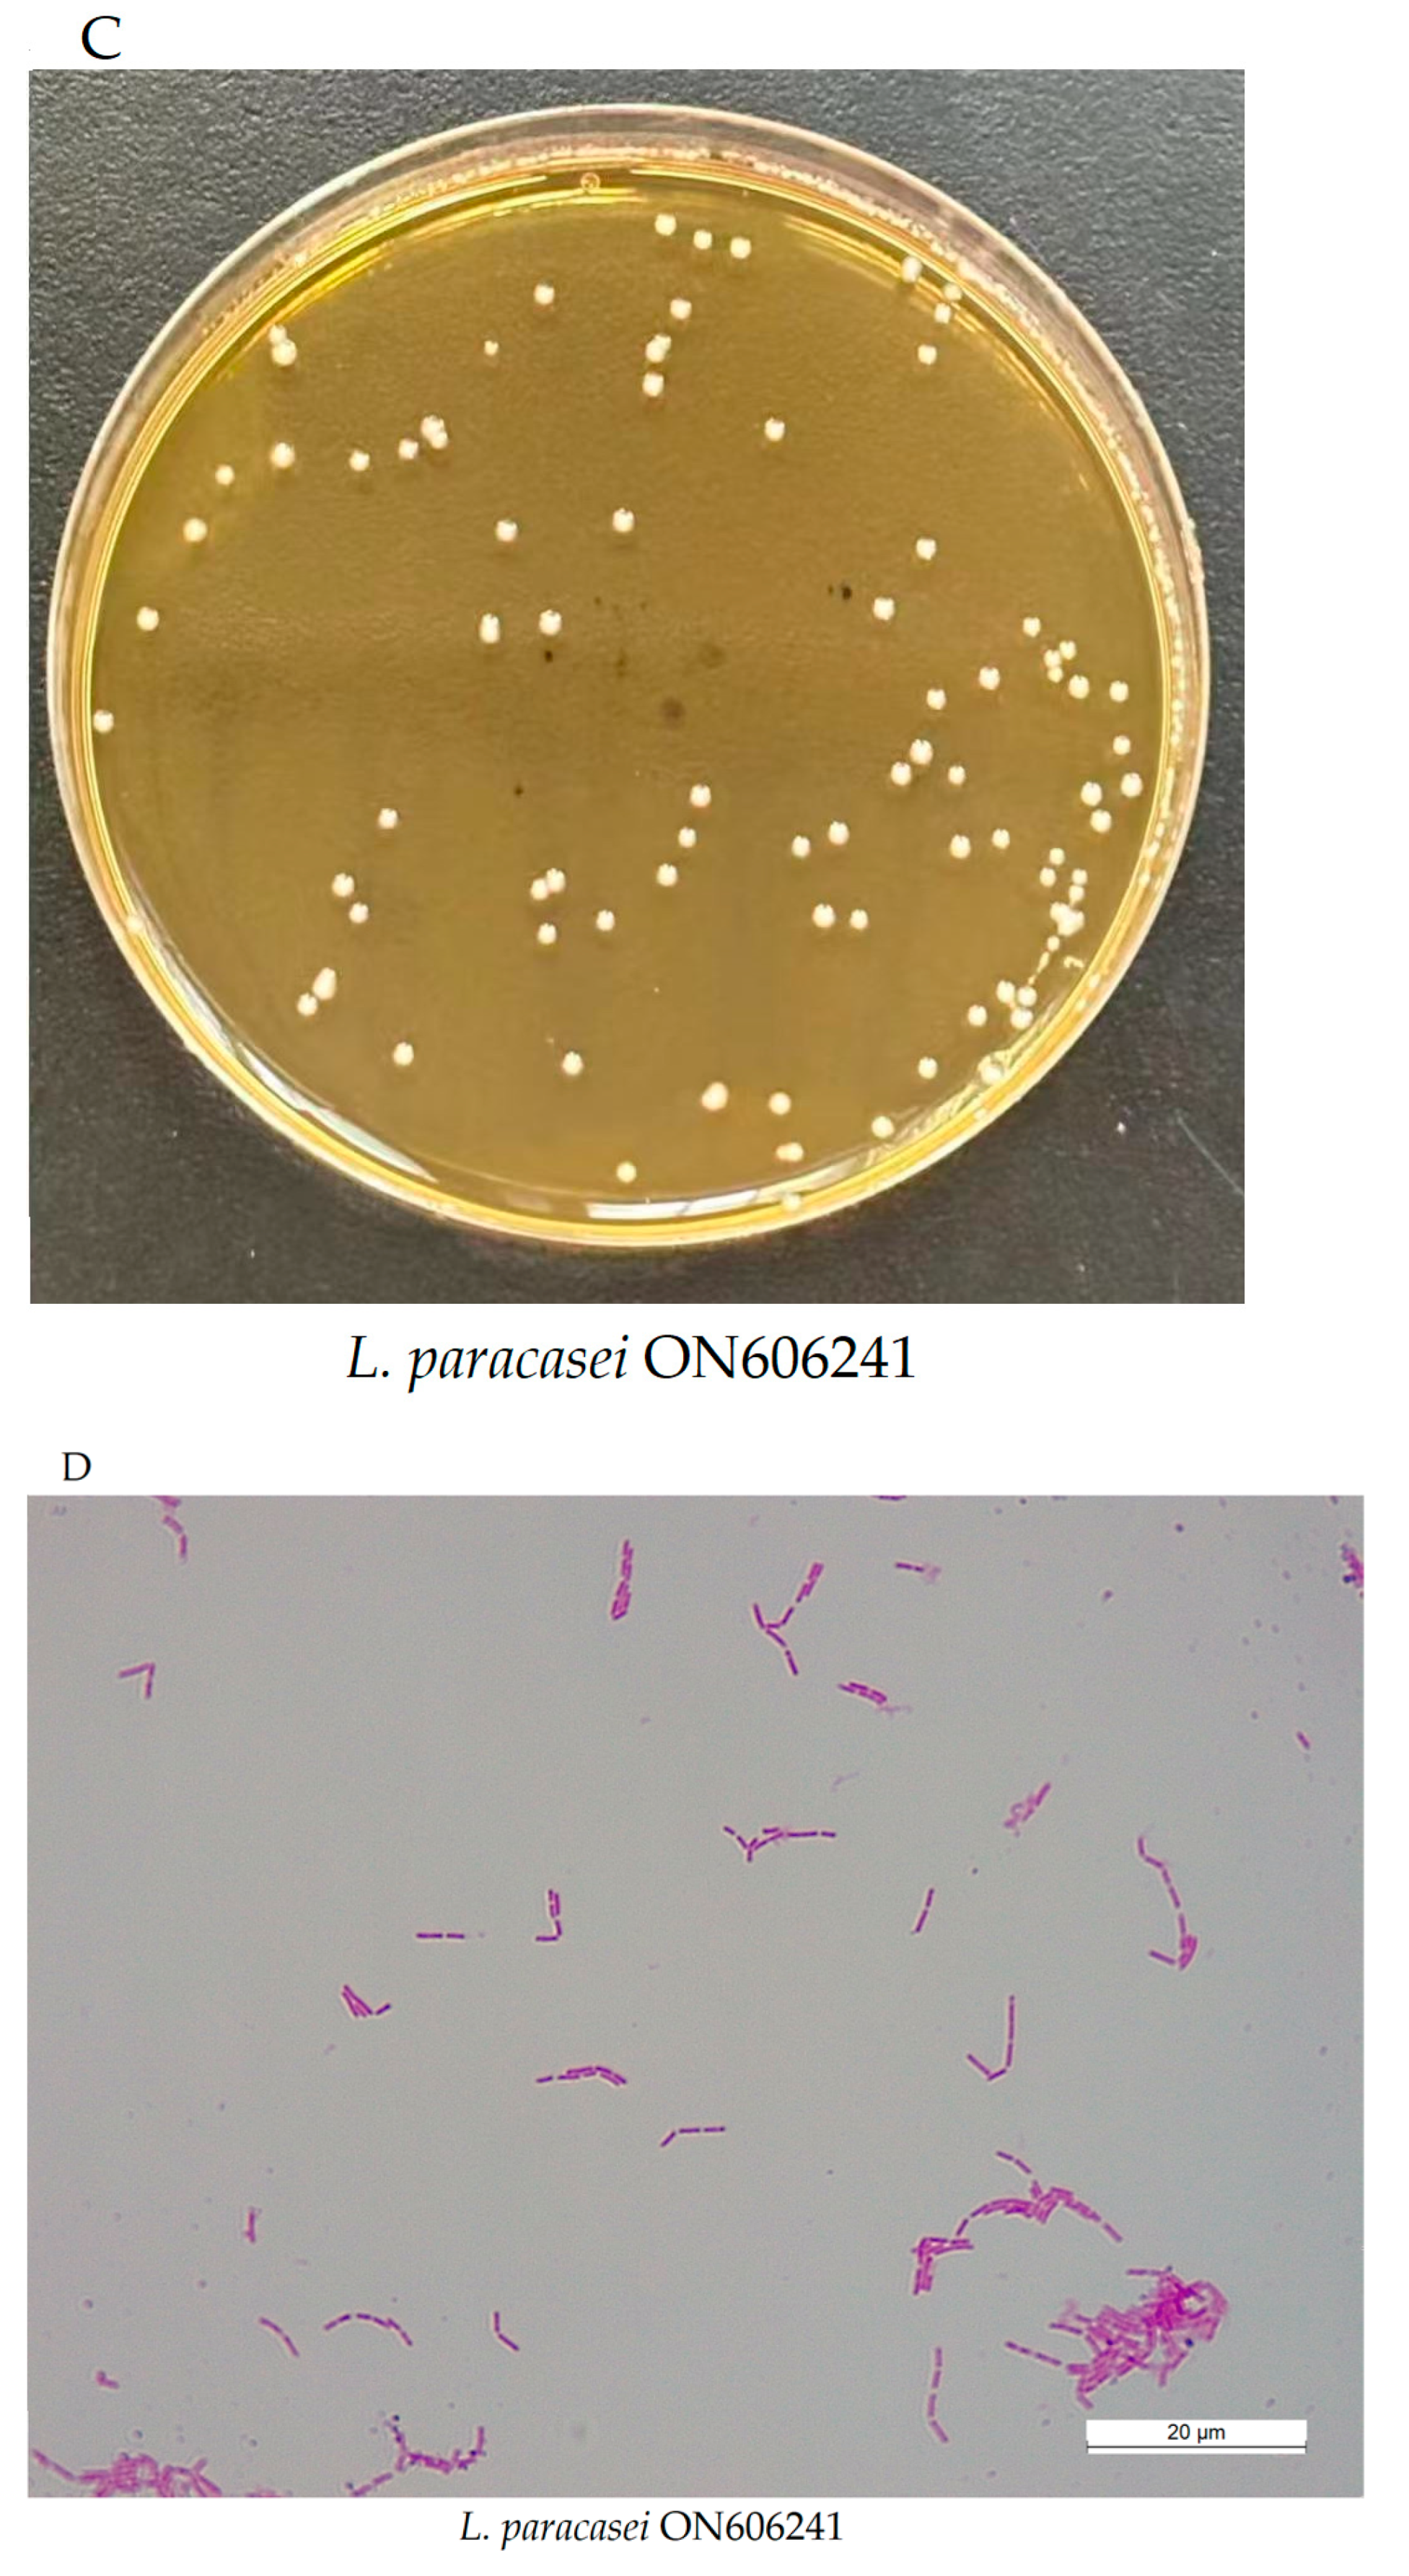
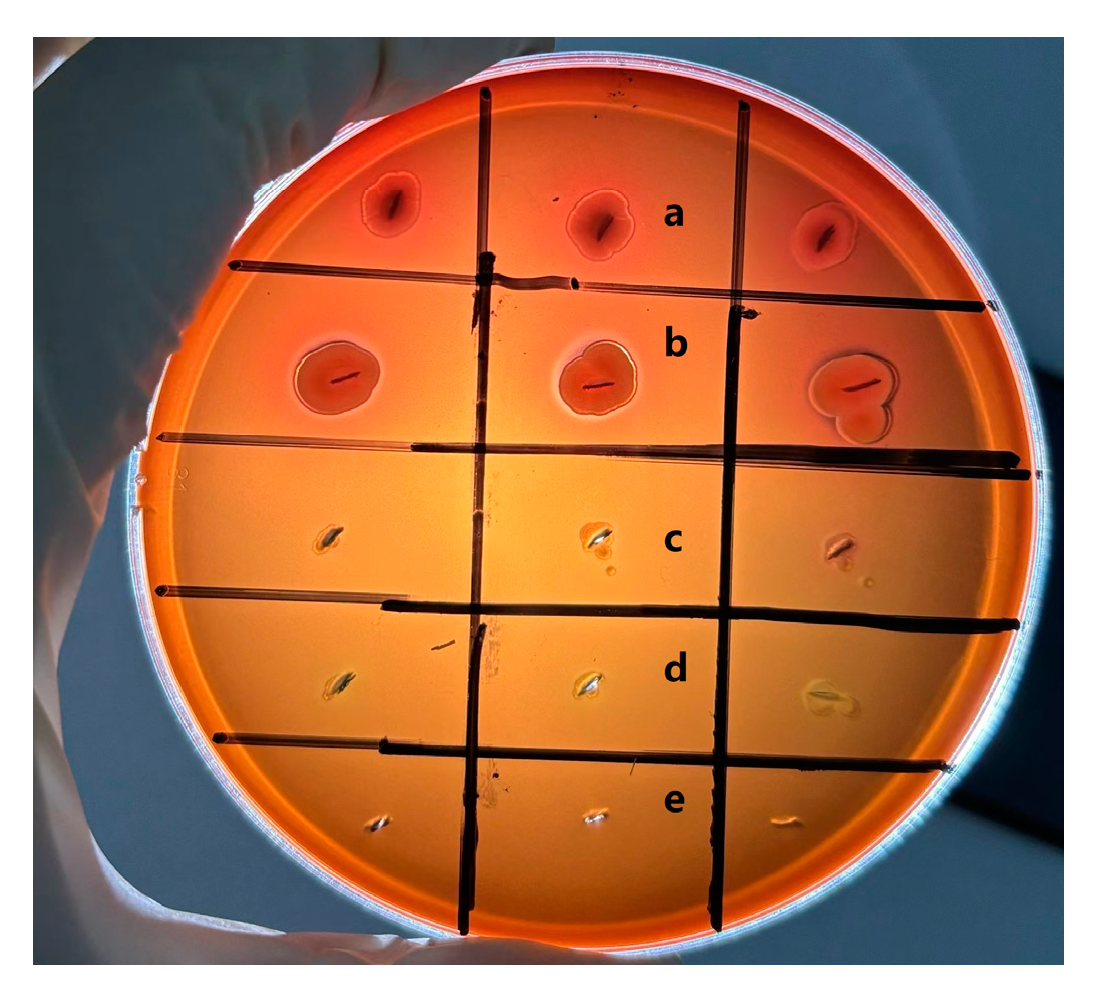

Exploring CAZymes Differences in Pediococcus acidilactici Strain OM681363 and Lacticaseibacillus paracasei Strain ON606241 Based on Whole-Genome Sequencing
Abstract
1. Introduction
2. Materials and Methods
2.1. Strains
2.2. Biological Identification of Strains
2.2.1. Revival and Morphological Observations of Strains
2.2.2. Catalase Activity and Hemolysis Test
2.2.3. Growth Curves and Gas Production Monitoring
2.2.4. Chemical Parameter Determination
2.3. Whole-Genome Sequencing
2.3.1. Sequencing Methods
2.3.2. Gene Analysis and Prediction
2.3.3. Gene Function Annotation
2.4. Identification of Carbohydrate Degradation Ability
2.4.1. Growth with Pure Fiber Source
2.4.2. Corn Straw Degradation Rate
2.5. Statistical Analysis
3. Results
3.1. Basic Biological Identification
3.2. Bacterial Genome-Wide Analysis
3.2.1. Basic Genome-Wide Features
3.2.2. Non-Coding RNA
3.2.3. CRISPR Prediction
3.2.4. Genome-Wide Gene Prediction and Functional Annotation
3.2.5. Comparison of Carbohydrate Synthesis and Degradation Enzyme
3.2.6. Fibrous Carbohydrate Degradation Ability
4. Discussion
5. Conclusions
Author Contributions
Funding
Institutional Review Board Statement
Informed Consent Statement
Data Availability Statement
Conflicts of Interest
References
- Peng, C.; Sun, W.; Dong, X.; Zhao, L.; Hao, J. Isolation, Identification and Utilization of Lactic Acid Bacteria from Silage in a Warm and Humid Climate Area. Sci. Rep. 2021, 11, 12586. [Google Scholar] [CrossRef]
- Quilodrán-Vega, S.R.; Muñoz-Flores, C.; Pino, A.; Buldres, P.; Sandoval, F.; Aguirre, A.; Portillo, B.; Parra, N.; Altamirano, C.; Albarracín, L.; et al. Isolation, Characterization, and Immunomodulatory Activity Evaluation of Probiotic Strains from Colostrum and Canine Milk. Front. Vet. Sci. 2023, 10, 1266064. [Google Scholar] [CrossRef]
- Keresztény, T.; Libisch, B.; Orbe, S.C.; Nagy, T.; Kerényi, Z.; Kocsis, R.; Posta, K.; Papp, P.P.; Olasz, F. Isolation and Characterization of Lactic Acid Bacteria with Probiotic Attributes from Different Parts of the Gastrointestinal Tract of Free-Living Wild Boars in Hungary. Probiot. Antimicrob. Proteins 2024, 16, 1221–1239. [Google Scholar] [CrossRef] [PubMed]
- Li, J.; Wang, W.; Chen, S.; Shao, T.; Tao, X.; Yuan, X. Effect of Lactic Acid Bacteria on the Fermentation Quality and Mycotoxins Concentrations of Corn Silage Infested with Mycotoxigenic Fungi. Toxins 2021, 13, 699. [Google Scholar] [CrossRef]
- Nishiyama, K.; Sugiyama, M.; Mukai, T. Adhesion Properties of Lactic Acid Bacteria on Intestinal Mucin. Microorganisms 2016, 4, 34. [Google Scholar] [CrossRef] [PubMed]
- Han, X.; Ding, S.; Ma, Y.; Fang, J.; Jiang, H.; Li, Y.; Liu, G. Lactobacillus plantarum and Lactobacillus brevis Alleviate Intestinal Inflammation and Microbial Disorder Induced by ETEC in a Murine Model. Oxid. Med. Cell. Longev. 2021, 2021, 6867962. [Google Scholar] [CrossRef] [PubMed]
- Silva, L.F.; Sunakozawa, T.N.; Monteiro, D.A.; Casella, T.; Conti, A.C.; Todorov, S.D.; Penna, A.L.B. Potential of Cheese-Associated Lactic Acid Bacteria to Metabolize Citrate and Produce Organic Acids and Acetoin. Metabolites 2023, 13, 1134. [Google Scholar] [CrossRef]
- Mansour, N.M.; Elkalla, W.S.; Ragab, Y.M.; Ramadan, M.A. Inhibition of Acetic Acid-Induced Colitis in Rats by New Pediococcus Acidilactici Strains, Vitamin Producers Recovered from Human Gut Microbiota. PLoS ONE 2021, 16, 0255092. [Google Scholar] [CrossRef] [PubMed]
- Fugaban, J.I.I.; Bucheli, J.E.V.; Kim, B.; Holzapfel, W.H.; Todorov, S.D. Safety and Beneficial Properties of Bacteriocinogenic Pediococcus acidilactici and Pediococcus pentosaceus Isolated from Silage. Lett. Appl. Microbiol. 2021, 73, 725–734. [Google Scholar] [CrossRef]
- Fugaban, J.I.I.; Bucheli, J.E.V.; Park, Y.J.; Suh, D.H.; Jung, E.S.; Ivanova, I.V.; Holzapfel, W.H.; Todorov, S.D. Antimicrobial Properties of Pediococcus acidilactici and Pediococcus pentosaceus Isolated from Silage. J. Appl. Microbiol. 2022, 132, 311–330. [Google Scholar] [CrossRef] [PubMed]
- Pfeiler, E.A.; Klaenhammer, T.R. The Genomics of Lactic Acid Bacteria. Trends Microbiol. 2017, 15, 546–553. [Google Scholar] [CrossRef]
- Hu, G.; Jiang, H.; Zong, Y.; Datsomor, O.; Kou, L.; An, Y.; Zhao, J.; Miao, L. Characterization of Lactic Acid-Producing Bacteria Isolated from Rumen: Growth, Acid and Bile Salt Tolerance, and Antimicrobial Function. Fermentation 2022, 8, 385. [Google Scholar] [CrossRef]
- Xie, J.; Chen, Y.; Cai, G.; Cai, R.; Hu, Z.; Wang, H. Tree Visualization By One Table (tvBOT): A Web Application for Visualizing, Modifying and Annotating Phylogenetic Trees. Nucleic Acids Res. 2023, 51, W587–W592. [Google Scholar] [CrossRef] [PubMed]
- Menke, K.H.; Raab, L.; Salewski, A.; Steingass, H.; Fritz, D.; Schneider, W. The Estimation of the Digestibility and Metabolizable Energy Content of Ruminant Feedingstuffs from the Gas Production When They Are Incubated with Rumen Liquor in Vitro. J. Agric. Sci. Camb. 1979, 93, 217–222. [Google Scholar] [CrossRef]
- Piwat, S.; Teanpaisan, R.; Dahlén, G.; Thitasomakul, S.; Douglas, C.W.I. Acid Production and Growth by Oral Lactobacillus Species in Vitro. J. Investig. Clin. Dent. 2012, 3, 56–61. [Google Scholar] [CrossRef]
- Kang, W.; Pan, L.; Peng, C.; Dong, L.; Cao, S.; Cheng, H.; Wang, Y.; Zhang, C.; Gu, R.; Wang, J.; et al. Isolation and Characterization of Lactic Acid Bacteria from Human Milk. J. Dairy Sci. 2020, 103, 9980–9991. [Google Scholar] [CrossRef] [PubMed]
- Li, C.; Wang, S.; Chen, S.; Wang, X.; Deng, X.; Liu, G.; Chang, W.; Beckers, Y.; Cai, H. Screening and Characterization of Pediococcus acidilactici LC-9-1 toward Selection as a Potential Probiotic for Poultry with Antibacterial and Antioxidative Properties. Antioxidants 2023, 12, 215. [Google Scholar] [CrossRef]
- Gueimonde, M.; Sánchez, B.; de Los Reyes-Gavilán, C.G.; Margolles, A. Antibiotic Resistance in Probiotic Bacteria. Front. Microbiol. 2013, 4, 202. [Google Scholar] [CrossRef]
- Ennahar, S.; Cai, Y.; Fujita, Y. Phylogenetic Diversity of Lactic Acid Bacteria Associated with Paddy Rice Silage as Determined by 16S Ribosomal DNA Analysis. Appl. Environ. Microbiol. 2003, 69, 444–451. [Google Scholar] [CrossRef] [PubMed]
- Xu, Z.; Zhang, S.; Zhang, R.; Li, S.; Kong, J. The Changes in Dominant Lactic Acid Bacteria and Their Metabolites during Corn Stover Ensiling. J. Appl. Microbiol. 2018, 125, 675–685. [Google Scholar] [CrossRef]
- Danner, H.; Holzer, M.; Mayrhuber, E.; Braun, R. Acetic Acid Increases Stability of Silage under Aerobic Conditions. Appl. Environ. Microbiol. 2003, 69, 562–567. [Google Scholar] [CrossRef] [PubMed]
- Killerby, M.A.; Almeida, S.T.R.; Hollandsworth, R.; Guimaraes, B.C.; Leon-Tinoco, A.; Perkins, L.B.; Henry, D.; Schwartz, T.J.; Romero, J.J. Effect of Chemical and Biological Preservatives and Ensiling Stage on the Dry Matter Loss, Nutritional Value, Microbial Counts, and Ruminal in Vitro Gas Production Kinetics of Wet Brewer’s Grain Silage. J. Anim. Sci. 2022, 100, skac095. [Google Scholar] [CrossRef] [PubMed]
- Hwanhlem, N.; Salaipeth, L.; Charoensook, R.; Kanjan, P.; Maneerat, S. Lactic Acid Bacteria from Gamecock and Goat Originating from Phitsanulok, Thailand: Isolation, Identification, Technological Properties and Probiotic Potential. J. Microbiol. Biotechnol. 2022, 32, 355–364. [Google Scholar] [CrossRef]
- Daniel, J.L.P.; Queiroz, O.C.M.; Arriola, K.G.; Daetz, R.; Basso, F.; Romero, J.J.; Adesogan, A.T. Effects of Homolactic Bacterial Inoculant on the Performance of Lactating Dairy Cows. J. Dairy Sci. 2018, 101, 5145–5152. [Google Scholar] [CrossRef] [PubMed]
- Rombouts, J.L.; Kranendonk, E.M.M.; Regueira, A.; Weissbrodt, D.G.; Kleerebezem, R.; Van Loosdrecht, M.C.M. Selecting for Lactic Acid Producing and Utilising Bacteria in Anaerobic Enrichment Cultures. Biotech Bioeng. 2020, 117, 1281–1293. [Google Scholar] [CrossRef] [PubMed]
- Li, Z.; Song, Q.; Wang, M.; Ren, J.; Liu, S.; Zhao, S. Comparative Genomics Analysis of Pediococcus acidilactici Species. J. Microbiol. 2021, 59, 573–583. [Google Scholar] [CrossRef] [PubMed]
- Mu, Y.; Zhang, C.; Li, T.; Jin, F.-J.; Sung, Y.-J.; Oh, H.-M.; Lee, H.-G.; Jin, L. Development and Applications of CRISPR/Cas9-Based Genome Editing in Lactobacillus. Int. J. Mol. Sci. 2022, 23, 12852. [Google Scholar] [CrossRef]
- Niu, T.; Jiang, Y.; Fan, S.; Yang, G.; Shi, C.; Ye, L.; Wang, C. Antiviral Effects of Pediococcus acidilactici Isolated from Tibetan Mushroom and Comparative Genomic Analysis. Front. Microbiol. 2022, 13, 1069981. [Google Scholar] [CrossRef]
- Puchart, V.; Biely, P. Microbial Xylanolytic Carbohydrate Esterases. Essays Biochem. 2023, 67, 479–491. [Google Scholar]
- Cheng, X.; Liu, X.; Jordan, K.W.; Yu, J.; Whitworth, R.J.; Park, Y.; Chen, M.-S. Frequent Acquisition of Glycoside Hydrolase Family 32 (GH32) Genes from Bacteria via Horizontal Gene Transfer Drives Adaptation of Invertebrates to Diverse Sources of Food and Living Habitats. Int. J. Mol. Sci. 2024, 25, 8296. [Google Scholar] [CrossRef]
- Xue, M.-Y. Investigation of Fiber Utilization in the Rumen of Dairy Cows Based on Metagenome-Assembled Genomes and Single-Cell RNA Sequencing. Microbiome 2022, 10, 11. [Google Scholar] [CrossRef] [PubMed]
- Meier, K.K.; Jones, S.M.; Kaper, T.; Hansson, H.; Koetsier, M.J.; Karkehabadi, S.; Solomon, E.I.; Sandgren, M.; Kelemen, B. Oxygen Activation by Cu LPMOs in Recalcitrant Carbohydrate Polysaccharide Conversion to Monomer Sugars. Chem. Rev. 2018, 118, 2593–2635. [Google Scholar] [CrossRef] [PubMed]
- Forsberg, Z.; Sørlie, M.; Petrović, D.; Courtade, G.; Aachmann, F.L.; Vaaje-Kolstad, G.; Bissaro, B.; Røhr, Å.K.; Eijsink, V.G. Polysaccharide Degradation by Lytic Polysaccharide Monooxygenases. Curr. Opin. Struct. Biol. 2019, 59, 54–64. [Google Scholar] [CrossRef]
- Lombard, V.; Ramulu, H.; Drula, E.; Coutinho, P.M.; Henrissat, B. The Carbohydrate-Active Enzymes Database (CAZy) in 2013. Nucl. Acids Res. 2014, 42, D490–D495. [Google Scholar] [CrossRef]
- Wan, X.; SunKang, Y.; Chen, Y.; Zhang, Z.; Gou, H.; Xue, Y.; Wang, C.; Wei, Y.; Yang, Y. Co-Expression of Endoglucanase and Cellobiohydrolase from Yak Rumen in Lactic Acid Bacteria and Its Preliminary Application in Whole-Plant Corn Silage Fermentation. Front. Microbiol. 2024, 15, 1442797. [Google Scholar] [CrossRef] [PubMed]

| P. acidilactici OM681363 | L. paracasei ON606241 | |
|---|---|---|
| Gene number | 2068 | 3031 |
| Gene total length (kb) | 1,793,250 | 2,537,370 |
| GC content in gene region | 43.1% | 46.9% |
| ncRNA Type | Number | Average Len (bp) | Length/Genome (%) | |
|---|---|---|---|---|
| acidilactici OM681363 | tRNA | 56 | 75 | 0.2% |
| 5S rRNA | 1 | 115 | 0% | |
| 16S rRNA | 1 | 1565 | 0.07% | |
| 23S rRNA | 1 | 2921 | 0.14% | |
| L. paracasei ON606241 | tRNA | 54 | 75 | 0.13% |
| 5S rRNA | 1 | 116 | 0% | |
| 16S rRNA | 1 | 1467 | 0.04% | |
| 23S rRNA | 1 | 3652 | 0.12% |
| Start | End | RepeatNum | AverRepeatLen | SpacerNum | AverSpacerLen | |
|---|---|---|---|---|---|---|
| P. acidilactici OM681363 | 315,248 | 319,362 | 71 | 23 | 70 | 35 |
| 319,961 | 320,505 | 10 | 35 | 9 | 21 | |
| 53,989 | 55,344 | 21 | 36 | 20 | 30 | |
| L. paracasei ON606241 | 32,897 | 34,780 | 29 | 36 | 28 | 30 |
| Type | Enzymes | Strains | |
|---|---|---|---|
| P. acidilactici OM681363 | L. paracasei ON606241 | ||
| Polysaccharide lyases | PL8 | 0 | 1 |
| PL12 | 0 | 1 | |
| Glycosytransferases | GT2 | 9 | 13 |
| GT4 | 6 | 11 | |
| GT5 | 0 | 1 | |
| GT8 | 2 | 2 | |
| GT26 | 1 | 0 | |
| GT27 | 1 | 0 | |
| GT28 | 1 | 1 | |
| GT32 | 1 | 1 | |
| GT35 | 0 | 1 | |
| GT51 | 2 | 3 | |
| GT83 | 0 | 1 | |
| Glycoside hydrolases | GH1 | 6 | 5 |
| GH2 | 3 | 0 | |
| GH3 | 1 | 2 | |
| GH4 | 0 | 1 | |
| GH13 | 0 | 8 | |
| GH18 | 1 | 0 | |
| GH20 | 0 | 1 | |
| GH23 | 1 | 0 | |
| GH25 | 2 | 6 | |
| GH29 | 2 | 3 | |
| GH31 | 2 | 2 | |
| GH32 | 0 | 2 | |
| GH35 | 1 | 1 | |
| GH36 | 0 | 2 | |
| GH38 | 2 | 2 | |
| GH39 | 0 | 1 | |
| GH43 | 1 | 0 | |
| GH63 | 2 | 0 | |
| GH65 | 0 | 1 | |
| GH73 | 2 | 1 | |
| GH78 | 2 | 0 | |
| GH88 | 0 | 1 | |
| GH94 | 0 | 1 | |
| GH109 | 1 | 3 | |
| GH123 | 1 | 0 | |
| GH125 | 1 | 1 | |
| GH136 | 0 | 1 | |
| GH170 | 2 | 0 | |
| Carbohydrate esterases | CE1 | 2 | 8 |
| CE2 | 1 | 1 | |
| CE3 | 1 | 0 | |
| CE4 | 0 | 1 | |
| CE5 | 2 | 0 | |
| CE7 | 1 | 0 | |
| CE9 | 2 | 2 | |
| CE10 | 0 | 4 | |
| CE12 | 0 | 1 | |
| Carbohydrate-binding modules | CBM16 | 1 | 0 |
| CBM32 | 1 | 0 | |
| CBM50 | 6 | 2 | |
| CBM56 | 1 | 0 | |
| Auxiliary activities | AA1 | 1 | 1 |
| AA3 | 0 | 2 | |
| AA4 | 0 | 1 | |
| AA6 | 2 | 2 | |
| AA7 | 1 | 2 | |
| AA10 | 1 | 0 | |
| Items | Control | P. acidilactici OM681363 | L. paracasei ON606241 | SE | p-Value |
|---|---|---|---|---|---|
| Degradation rate (72 h, %) | 59.63 | 65.63 | 58.32 | 4.43 | 0.21 |
| Gas production (mL/g DM) | |||||
| 24 h | 35.77 | 55.72 | 56.77 | 4.32 | 0.06 |
| 48 h | 53.94 | 88.34 | 94.51 | 11.99 | 0.06 |
| 72 h | 61.65 b | 119.91 a | 93.90 ab | 13.45 | 0.04 |
| VFA production (72 h, mmol/L) | |||||
| Acetic acid | 6.80 c | 12.64 b | 17.25 a | 0.58 | <0.01 |
| Propionic acid | 0.35 | 5.50 | 8.21 | 2.04 | 0.06 |
| Butyric acid | 2.67 b | 10.89 a | 3.26 b | 0.74 | <0.01 |
Disclaimer/Publisher’s Note: The statements, opinions and data contained in all publications are solely those of the individual author(s) and contributor(s) and not of MDPI and/or the editor(s). MDPI and/or the editor(s) disclaim responsibility for any injury to people or property resulting from any ideas, methods, instructions or products referred to in the content. |
© 2025 by the authors. Licensee MDPI, Basel, Switzerland. This article is an open access article distributed under the terms and conditions of the Creative Commons Attribution (CC BY) license (https://creativecommons.org/licenses/by/4.0/).
Share and Cite
Lin, M.; Jama, S.M.; Cheng, Z.; Zong, Y.; Su, Y.; Liu, W.; Liu, L. Exploring CAZymes Differences in Pediococcus acidilactici Strain OM681363 and Lacticaseibacillus paracasei Strain ON606241 Based on Whole-Genome Sequencing. Fermentation 2025, 11, 64. https://doi.org/10.3390/fermentation11020064
Lin M, Jama SM, Cheng Z, Zong Y, Su Y, Liu W, Liu L. Exploring CAZymes Differences in Pediococcus acidilactici Strain OM681363 and Lacticaseibacillus paracasei Strain ON606241 Based on Whole-Genome Sequencing. Fermentation. 2025; 11(2):64. https://doi.org/10.3390/fermentation11020064
Chicago/Turabian StyleLin, Miao, Shakib Mohamed Jama, Zhiqiang Cheng, Yujie Zong, Yanjing Su, Wengboyang Liu, and Li Liu. 2025. "Exploring CAZymes Differences in Pediococcus acidilactici Strain OM681363 and Lacticaseibacillus paracasei Strain ON606241 Based on Whole-Genome Sequencing" Fermentation 11, no. 2: 64. https://doi.org/10.3390/fermentation11020064
APA StyleLin, M., Jama, S. M., Cheng, Z., Zong, Y., Su, Y., Liu, W., & Liu, L. (2025). Exploring CAZymes Differences in Pediococcus acidilactici Strain OM681363 and Lacticaseibacillus paracasei Strain ON606241 Based on Whole-Genome Sequencing. Fermentation, 11(2), 64. https://doi.org/10.3390/fermentation11020064

